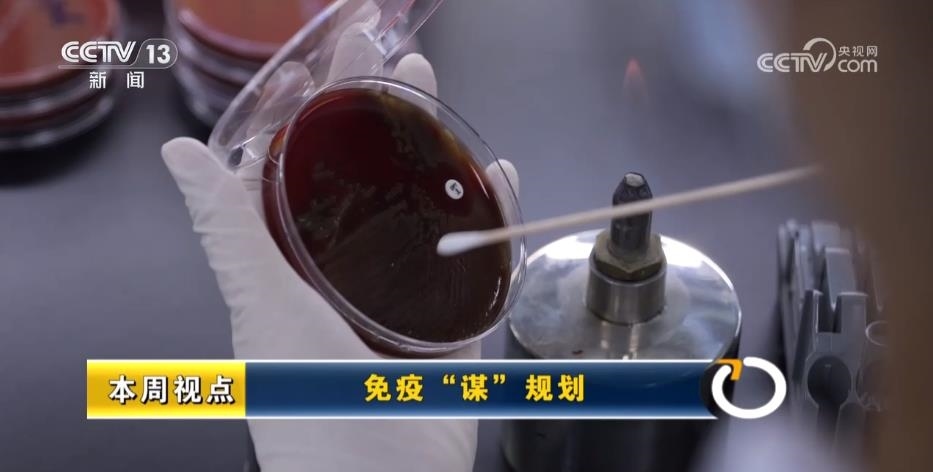

4月25日是我國第38個全國兒童預(yù)防接種日,每年4月最后一周也是世界衛(wèi)生組織設(shè)定的“世界免疫周”,希望通過不斷擴(kuò)大免疫規(guī)劃,讓疫苗保護(hù)更多人的健康。
今年是全球擴(kuò)大免疫規(guī)劃50周年,世衛(wèi)組織統(tǒng)計(jì),這項(xiàng)工作目前已挽救約1.54億人的生命,當(dāng)然,中國也為實(shí)現(xiàn)這一成績作出了重要貢獻(xiàn)。
從1978年啟動免疫規(guī)劃以來,各種免疫規(guī)劃的疫苗已避免了3億多例脊灰、白喉、乙肝等病例,并且,中國還從疫苗受捐國變成了捐贈國,在保護(hù)本國國民的同時也在造福全球百姓。
《新聞周刊》本周視點(diǎn)關(guān)注,如何更好地用疫苗,為我們的健康保駕護(hù)航。
我國實(shí)施計(jì)劃免疫
小兒麻痹等多種疾病被消除
本周四上午,深圳市婦幼保健院迎來一名新生兒。經(jīng)過擦拭檢查后,嬰兒的各項(xiàng)指標(biāo)都顯示健康。下午,家屬被告知,孩子當(dāng)天就需要接種第一針乙肝疫苗以及唯一一針卡介苗。
剛出生時是嬰兒抵抗力較薄弱的時候,為了能盡早產(chǎn)生免疫力,醫(yī)院一般建議12小時內(nèi)就完成接種,最晚不超過24小時。由于此次是二胎生育,父母對大致流程也比較熟悉。
預(yù)防接種證是每個孩子除了出生證以外的第二個證件,除了往后再打疫苗時,孩子入托入學(xué)時都需要持有這個憑證。自2002年,國家將乙型肝炎疫苗納入全國兒童計(jì)劃免疫中后,截至目前,在新生兒群體中的乙肝疫苗覆蓋率在90%以上,母嬰成功阻斷率達(dá)95% 。而中國作為發(fā)起免疫規(guī)劃項(xiàng)目最早、覆蓋規(guī)模最大的國家之一,從1978年就開始全面實(shí)施兒童計(jì)劃免疫,至今已有46年。
中華預(yù)防醫(yī)學(xué)會副會長兼秘書長、中國疾病預(yù)防控制中心研究員 馮子健:現(xiàn)在叫作免疫規(guī)劃,當(dāng)時叫作計(jì)劃免疫。計(jì)劃免疫所針對的傳染病疫苗,它的接種率不斷提高,相應(yīng)疾病的發(fā)病率也是持續(xù)地降低,很多疾病都是95%以上的下降。

國家免疫規(guī)劃如何擴(kuò)容?
2007年國家免疫規(guī)劃確定14個疫苗預(yù)防15個病種。
馮子健介紹,到了2007年,我們國家又進(jìn)一步擴(kuò)大了我們國家的計(jì)劃免疫,它所覆蓋的疾病就擴(kuò)大了?,F(xiàn)在除了脊灰小兒麻痹被消滅之外,其他的就像白喉,已經(jīng)將近20年沒有病例報告,也可以說它已經(jīng)在我們國內(nèi)被消除了。
擴(kuò)大免疫規(guī)劃項(xiàng)目是世界衛(wèi)生組織發(fā)起的一項(xiàng)倡議,中國在早期還是受捐國的身份,但隨著免疫規(guī)劃項(xiàng)目的優(yōu)異成果和技術(shù)的提升,我們自9年前開始,已經(jīng)成為疫苗捐助國。
此外,國家免疫規(guī)劃配套的法律法規(guī)、服務(wù)體系、信息系統(tǒng)等也日趨完善。2019年我國首創(chuàng)、全球首部疫苗管理法的出臺與生效,也為疫苗行業(yè)加強(qiáng)監(jiān)管提供了法律依據(jù)。據(jù)相關(guān)研究數(shù)據(jù)顯示,實(shí)施國家免疫規(guī)劃之后,針對的15種疾病之中7種,發(fā)病率較疫苗使用前下降了99%以上。
我國留守、流動兒童
疫苗接種率相對略低
浙江大學(xué)公共衛(wèi)生學(xué)院“百人計(jì)劃”研究員 徐小林:關(guān)于我們國家免疫規(guī)劃接種率,如果在理想情況下達(dá)到百分之百是有可能的,但是在真實(shí)的接種環(huán)境里面,我們會發(fā)現(xiàn)很多的兒童由于比方說他的身體健康原因、家庭的“疫苗猶豫”,有可能是因?yàn)樗闹饔^和客觀原因,并不能達(dá)到百分之百。如果我們把兒童進(jìn)行細(xì)分的話,就會發(fā)現(xiàn)在不同兒童之間可能會存在一些接種率的差異。
徐小林將兒童分為城市、流動、非留守和留守四類,通過對杭州市區(qū)和洛陽鄉(xiāng)村的樣本取證,他可以對這些地區(qū)的接種意愿和接受程度進(jìn)行分析,盡管這個差距在不斷縮小,但數(shù)據(jù)上還是有細(xì)微差異。
徐小林:農(nóng)村留守兒童選取的是我國中部的河南,它是一個人口流出的代表省份。城市地區(qū)選擇的是浙江省,它是一個人口流入的代表性省份。我們發(fā)現(xiàn)這四類兒童的疫苗認(rèn)知情況,是呈現(xiàn)下降的趨勢,比方說留守兒童和流動兒童,他們的接種率雖然超過了90%,但是很多疫苗接種是有延遲的。這里面我們有一個衡量指標(biāo)叫作及時接種率,相對就要低一些,這也是“疫苗猶豫”的一個體現(xiàn)。

徐小林在研究當(dāng)中發(fā)現(xiàn),留守和流動兒童接種率相對略低的一個主要原因,是由于照護(hù)者疫苗認(rèn)知情況,其中非免疫規(guī)劃疫苗的注射率更受影響。根據(jù)這一發(fā)現(xiàn),他和研究農(nóng)村及城市的社區(qū)醫(yī)院都保持著溝通,定期一起對目標(biāo)區(qū)域人群做疫苗健康類別的干預(yù)普及,通過家庭、社區(qū)、社會力量的合作,繼而夯實(shí)周邊人群的免疫認(rèn)知。
本周四,全國兒童預(yù)防接種日,杭州蕭山區(qū)的這所社區(qū)醫(yī)院中,也開始了本周的科普講座。
杭州蕭山區(qū)紅山社區(qū)衛(wèi)生服務(wù)中心副主任 沈伊娜:我們國家免費(fèi)為適齡兒童提供的免疫規(guī)劃疫苗,還有非免疫規(guī)劃的疫苗,是同等重要的,因?yàn)樗A(yù)防的是不同的疾病。
17年前,我國已經(jīng)形成了“14苗防15病”的免疫規(guī)劃格局。近些年,一些新的針對比較嚴(yán)重疾病的疫苗不斷問世。對此,有關(guān)部門也多次表示將考慮擴(kuò)大免疫規(guī)劃的疫苗種類,國務(wù)院印發(fā)的《擴(kuò)大內(nèi)需戰(zhàn)略規(guī)劃綱要(2022—2035)》更是明確提到“逐步將安全、有效、財政可負(fù)擔(dān)的疫苗納入國家免疫規(guī)劃”,還建立了國家免疫規(guī)劃專家咨詢委員會,論證和推動國家免疫規(guī)劃擴(kuò)容,這些都是可喜的進(jìn)展。當(dāng)然,嚴(yán)謹(jǐn)?shù)募膊?shù)據(jù)統(tǒng)計(jì)和疫苗效果論證是免疫規(guī)劃擴(kuò)容的基礎(chǔ),為此,社會各界正在不斷探索。
我國正在推動肺炎鏈球菌類疫苗
進(jìn)入免疫規(guī)劃
2歲10個月的小李由于肺炎,發(fā)生兩次驚厥,住進(jìn)了海南省兒童醫(yī)院。在得到小李媽媽的同意后,醫(yī)生把他推薦到了一個特別的項(xiàng)目。護(hù)士對小李的兩個鼻腔采樣,隨后立即送到實(shí)驗(yàn)室培養(yǎng)。他們希望在所有常見的、能夠引發(fā)兒童呼吸道感染的病原體中,篩查出究竟是哪一個讓小李患上了肺炎。
國家傳染病醫(yī)學(xué)中心(上海)華山醫(yī)院感染科副教授 艾靜文:我們做的這個項(xiàng)目,更多的是一個廣篩,到底哪些病原體容易導(dǎo)致兒童呼吸道感染,希望拿到一個非常客觀的數(shù)據(jù),所以只要兒童符合我們的入組標(biāo)準(zhǔn),都會盡可能建議他入組完成這個免費(fèi)的監(jiān)測。一是給兒童、患者家長有一個報告,可以指導(dǎo)精準(zhǔn)治療。二是能為后續(xù)疫苗免疫規(guī)劃策略的制定提供一些科學(xué)依據(jù)。
艾靜文醫(yī)生來自上海的華山醫(yī)院感染科。在國家傳染病醫(yī)學(xué)中?、海南省疾控中心等多家機(jī)構(gòu)的支持下,2022年開始,她在海南的??凇⑷f寧、白沙三地,主持一個為期四年的針對肺炎鏈球菌的防控項(xiàng)目。數(shù)據(jù)顯示,肺炎鏈球菌是導(dǎo)致兒童重癥肺炎的首要病原菌,全球每年約有80萬名5歲以下兒童死于肺炎,其中58%就是由肺炎鏈球菌造成的,因此它也被稱為“5歲以下兒童的頭號殺手”。艾靜文的研究目標(biāo)之一就是要搞清楚,我國5歲以下兒童肺炎中,有多少也是由肺炎鏈球菌導(dǎo)致的。
海南省婦女兒童醫(yī)學(xué)中心兒童感染科主任 林道炯:肺炎鏈球菌它不僅可以引起兒童肺炎,還出現(xiàn)腦膜炎、敗血癥等并發(fā)癥。這些疾病往往比較危重,有時候會造成孩子不幸身亡,即使能夠救活,有時候也會留下一些智力低下、癱瘓、聽力下降等后遺癥。最近我們就接診過兩個孩子,后面還需要做開胸手術(shù)才最后得到痊愈。
肺炎鏈球菌主要通過打噴嚏、咳嗽等飛沫傳播。它通常定植在?體?咽部,平時不會興風(fēng)作浪,一旦人體遭遇麻疹、流感等病毒感染,或機(jī)體抵抗力下降時,就會趁機(jī)添亂、“補(bǔ)上一刀”,引發(fā)更嚴(yán)重的臨床疾病。
世界范圍內(nèi)目前較為有效的預(yù)防手段就是注射肺炎鏈球菌結(jié)合疫苗。它被世界衛(wèi)生組織列為“極優(yōu)先推薦疫苗”,已經(jīng)被168個國家納入免疫規(guī)劃。該病種疫苗能否在我國也起到保護(hù)作用,則是艾靜文在項(xiàng)目第二階段要重點(diǎn)關(guān)注的。
中華預(yù)防醫(yī)學(xué)會副會長兼秘書長、中國疾病預(yù)防控制中心研究員 馮子健:主要是為了增強(qiáng)我們的證據(jù)說服力,因?yàn)槲覀円匆呙缢诓煌膰摇⒉煌巳褐幸呙绲谋Wo(hù)特征有沒有差異,是不是在中國這樣的背景之下,它仍然有國外報道那樣的保護(hù)效率的水平,當(dāng)然也包括它的安全性。

目前,我國已經(jīng)掌握自主研發(fā)和生產(chǎn)13價肺炎球菌多糖結(jié)合疫苗。國內(nèi)批準(zhǔn)上市的三種13價肺炎疫苗產(chǎn)品中,有兩款就是國產(chǎn)。但無論國產(chǎn)還是進(jìn)口,都是自費(fèi)的二類疫苗,價格偏貴。在位于福建泉州晉江市的一家預(yù)防接種門診,記者看到,完成全程接種需要注射四針,國產(chǎn)的2500多元,進(jìn)口的2900多元,家長的接種愿意并不高。
馮子健:沒有納入免疫規(guī)劃的疫苗,價格相對來說都比較貴,那么可能很大程度上會影響到一些低收入家庭的接種意愿,所以我們得把它納入到免疫規(guī)劃。特別是針對這些比較嚴(yán)重的疾病,重要的疾病要加快進(jìn)程。
艾靜文在海南收集的數(shù)據(jù),本周,已正式進(jìn)入中期分析。初步結(jié)果顯示,在海南,導(dǎo)致兒童肺炎占比最高的病原體,同樣也是肺炎鏈球菌。他們表示,下一步將多方爭取資源,為??凇⑷f寧、白沙的適齡兒童免費(fèi)接種疫苗。如果臨床效果能夠明確疫苗確實(shí)降低了兒童相關(guān)疾病的發(fā)病率,那么就有可能更快推動該類疫苗進(jìn)入我國的免疫規(guī)劃中。屆時受益的也將不僅僅是兒童群體。
國家傳染病醫(yī)學(xué)中心(上海)華山醫(yī)院感染科副教授 艾靜文:中國很多老人帶孩子帶得多,發(fā)現(xiàn)小孩子得了肺炎鏈球菌之后,他的爺爺奶奶、外公外婆生病了,所以說我們推崇孩子盡快接種疫苗,也是覺得還能從側(cè)面對家里同居的老人、一些免疫低下的人有一些保護(hù)的作用。
預(yù)防宮頸癌
HPV疫苗免費(fèi)接種還有多遠(yuǎn)?
這些年,HPV疫苗接種預(yù)防宮頸癌一直有著相當(dāng)?shù)脑掝}熱度,宮頸癌也有望成為第一個被消除的癌癥。國家衛(wèi)健委等十部門印發(fā)的《加速消除宮頸癌行動計(jì)劃(2023—2030年)》提出,目標(biāo)到2025年,試點(diǎn)推廣適齡女孩HPV疫苗接種服務(wù)。其實(shí)在幾年前,一些地方就已開始探索HPV疫苗免費(fèi)接種的惠民政策。
72歲的段仙芝時常奔波于北京、內(nèi)蒙古兩地。生于準(zhǔn)格爾旗的她,十幾歲時常聽說老人會得一種“倒開花”的不治之癥,做了婦科醫(yī)生才知道,那是女性絕經(jīng)后出血,大部分出血都能治,致死的只有宮頸癌。她曾在產(chǎn)科辛苦接生,迎接希望,但最終還是跟打小就耳聞過的宮頸癌產(chǎn)生了聯(lián)系。20世紀(jì)80年代,段仙芝到北京的醫(yī)院進(jìn)修,接觸了大量宮頸癌病例。
首都醫(yī)科大學(xué)附屬北京同仁醫(yī)院婦產(chǎn)科主任醫(yī)師 段仙芝:宮頸癌早期是沒有任何癥狀,它就是沉默的殺手一樣,等它出現(xiàn)了癥狀以后就是晚期,經(jīng)過篩查能夠得到早期診斷和治療。
沒有宮頸癌疫苗的年代,高效價廉的篩查技術(shù)是國際急需的宮頸癌防治手段。喬友林和團(tuán)隊(duì)研發(fā)的一項(xiàng)快速篩查技術(shù),成本僅為發(fā)達(dá)國家普遍使用技術(shù)的1/10,并獲世衛(wèi)組織資格認(rèn)證,為世界宮頸癌防治輸出“中國智慧”。2004年,經(jīng)介紹他與段仙芝結(jié)識,幫助支持她在內(nèi)蒙古對成年婦女開展宮頸癌篩查工作。

段仙芝:我說喬老師,我要查一查,到底內(nèi)蒙古的東中西、民族、年齡,還有發(fā)病情況之間的關(guān)系,想從東到西查10萬人,給大家留下一個真實(shí)的宮頸癌篩查數(shù)據(jù),一共是做了120620人 。
鄂爾多斯市發(fā)展和改革委員會副主任(時任準(zhǔn)格爾旗人民政府副旗長) 張銀銀:我們前期篩查工作做得也好,黨委政府認(rèn)為我們要實(shí)現(xiàn)消除宮頸癌的目標(biāo),疫苗注射是其中重要一環(huán),這是惠及婦女群眾的一項(xiàng)民生實(shí)事。尤其當(dāng)?shù)馗咧挟厴I(yè)的孩子馬上要進(jìn)入社會了,可能病毒感染風(fēng)險性也更大,從人數(shù)上來說,增加了一部分,增加的財政負(fù)擔(dān)也不算重。
2020年8月1日,準(zhǔn)格爾旗啟動“關(guān)愛女生健康進(jìn)校園”,2020年底,全旗13—18歲女生的接種率就超過了85%,并很快在鄂爾多斯全市鋪開。
2020年底,世衛(wèi)組織發(fā)布《加速消除宮頸癌全球戰(zhàn)略》,首次承諾消除一種癌癥。該全球戰(zhàn)略提出要到2030年實(shí)現(xiàn)90%適齡女孩宮頸癌疫苗接種、70%成年婦女高精度宮頸癌篩查、90%宮頸疾病確診者得到治療的“90-70-90”目標(biāo),而準(zhǔn)格爾旗已基本實(shí)現(xiàn)這個目標(biāo)。對于該全球戰(zhàn)略中國對此表示支持。中國醫(yī)學(xué)科學(xué)院腫瘤醫(yī)院開展的衛(wèi)生經(jīng)濟(jì)學(xué)模型研究顯示,中國宮頸癌消除的最佳策略和路徑,國家免疫規(guī)劃是必經(jīng)之路。而要讓疫苗惠及每一個適齡女孩,需要解決疫苗供應(yīng)和價格等問題。

中國疫苗行業(yè)協(xié)會疫苗國際合作促進(jìn)分會副主任委員 杜珩:宮頸癌疫苗很缺,不光是在中國,同時在全球都是這樣的。在2015年和2017年這兩年分別跟中國的兩家疫苗企業(yè)進(jìn)行了合作,支持它們提高產(chǎn)能、提高質(zhì)量、加強(qiáng)質(zhì)量管理等幾個方面,還同時支持它們?nèi)⒓邮佬l(wèi)組織預(yù)認(rèn)證的工作。有了疫苗,它的價格或者這個制造成本就會下來,銷售價格才有可能支付得起。最近的一個省級招標(biāo)采購的例子,國產(chǎn)疫苗的價格已經(jīng)降到了單劑100塊錢以下。
鄂爾多斯市縣的宮頸癌疫苗免疫規(guī)劃探索,還帶動了一些地方的省市一級試點(diǎn)工作。截至2024年3月,宮頸癌疫苗在9個省級行政區(qū)納入了民生項(xiàng)目,此外,有近30個健康城市和20個低衛(wèi)生資源縣開展試點(diǎn)項(xiàng)目。
疫苗已經(jīng)幫助我們消滅了天花;消除了脊髓灰質(zhì)炎(即小兒麻痹癥);也幫助我們將麻疹、流腦等多種傳染病的發(fā)病率降至歷史最低水平,未來,我們需要讓更多的疫苗守護(hù)我們的健康,尤其是孩子們的健康。
期待在不久的將來,能夠通過擴(kuò)大免疫規(guī)劃,使每一個人都能得到疫苗的保護(hù)。這樣的結(jié)果,需要政府的支持、醫(yī)學(xué)的努力、公益的探索、企業(yè)的創(chuàng)新以及公眾的廣泛參與。在這個過程中的每一點(diǎn)進(jìn)展,都標(biāo)志著我們離一個更健康的未來更近一步。
北疆新聞:內(nèi)蒙古自治區(qū)重點(diǎn)新聞網(wǎng)站(客戶端),內(nèi)蒙古出版集團(tuán)新華報業(yè)中心旗下國家互聯(lián)網(wǎng)新聞信息采編發(fā)布服務(wù)一類資質(zhì)網(wǎng)站(客戶端)。
北疆新聞版權(quán)與免責(zé)聲明:
一、凡本站中注明“來源:北疆新聞”的所有文字、圖片和音視頻,版權(quán)均屬北疆新聞所有,轉(zhuǎn)載時必須注明“來源:北疆新聞”,并附上原文鏈接。
二、凡來源非北疆新聞的新聞(作品)只代表本網(wǎng)傳播該消息,并不代表贊同其觀點(diǎn)。
如因作品內(nèi)容、版權(quán)和其它問題需要同本網(wǎng)聯(lián)系的,請?jiān)谝娋W(wǎng)后30日內(nèi)進(jìn)行,聯(lián)系郵箱:bjwmaster@163.com。
版權(quán)聲明:北疆新聞版權(quán)所有,未經(jīng)書面授權(quán),不得轉(zhuǎn)載或建立鏡像,違者依法必究。 本站違法和不良信息舉報電話:15648148811蒙ICP備16001043號-1
Copyright © 2016- 北疆新聞網(wǎng) All Rights Reserved互聯(lián)網(wǎng)新聞信息服務(wù)許可證:15120200009-1蒙公網(wǎng)安備:15010502001245